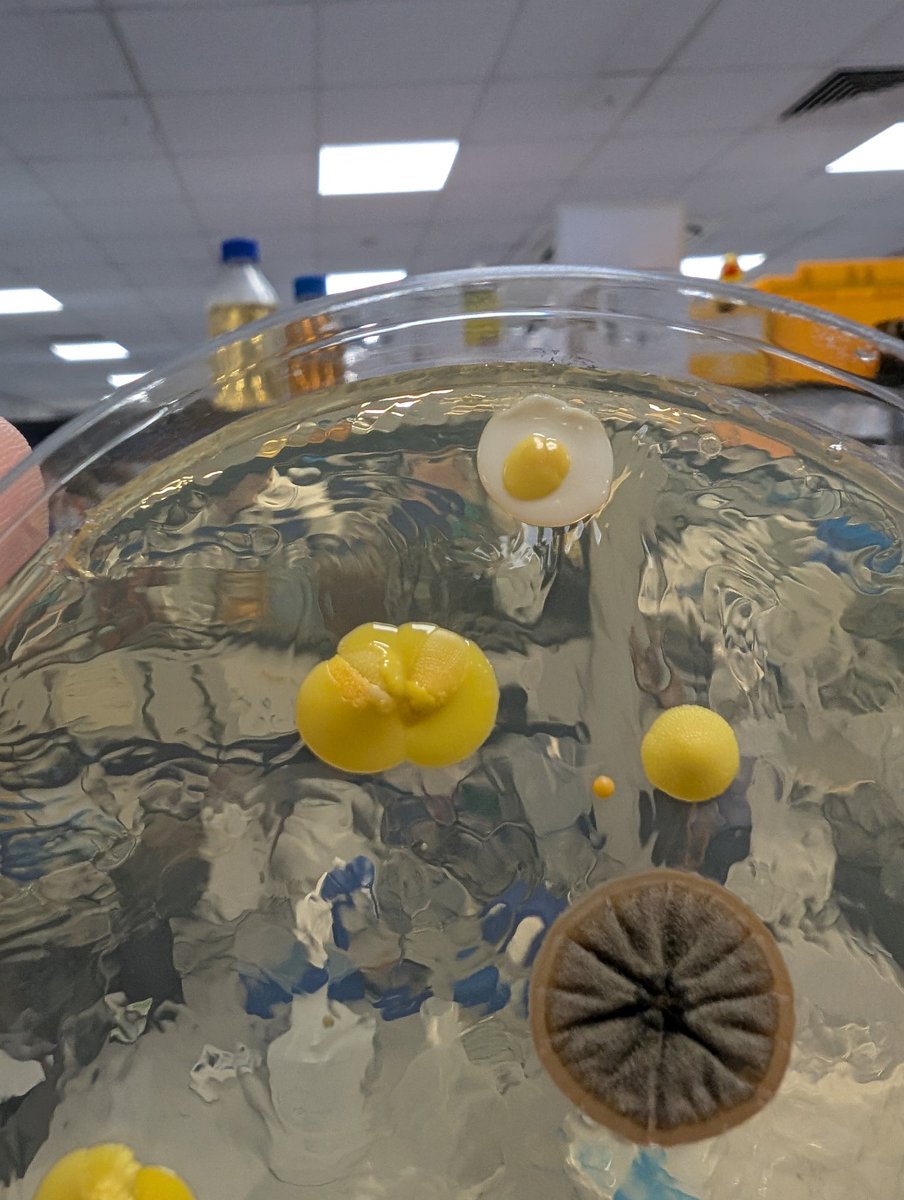
<a href="/ContamClub/">Contamination Club</a> the cutest little sunny side up contamination surprise in the lab this week 🐣

Dr. Kristi L. Frank
@kristilynnfrank
Microbiologist. Assoc. Prof. at Uniformed Services University. Marylander now. Minnesotan before. Montanan 1st and always. View are mine, not my employer's.
ID: 2730852499
14-08-2014 03:17:00
2,2K Tweet
780 Followers
552 Following




Get out of the lab and join the 2024 International Conference on Gram Positive Pathogens! Hosted by UNMC Pathology, Microbiology & Immunology Center for Staphylococcal Research (CSR). Early registration is ending on August 24. 📅 October 13-16, 2024 🏙️ Omaha, NE ✍️Register at shorturl.at/exhIX



🚨We are hiring!!🚨 UIC Microbiology has an open faculty search in any area of host-pathogen interactions. Apply by 10/31 to join us in the heart of Chicago! uic.csod.com/ux/ats/careers…




Our new review discusses the exquisite interactions of enterococci with diverse host tissues and how they shape the behavior of this pathobiont. Great to write this piece with Weema Madani Dr. Yusibeska Ramos and immuno guru Juan Cubillos-Ruiz Weill Cornell Medicine Ob/Gyn doi.org/10.1093/femsmc…

I am excited to announce several post-doc positions studying gene regulation and cell biology of spirochetes are available in the NIH Biology of Spirochetes Unit, opening 2025 in Bethesda, MD NIAID News! Join our team and work on the dynamic NIH campus: training.nih.gov/jobs/pdfi-0128…



Contamination Club the cutest little sunny side up contamination surprise in the lab this week 🐣